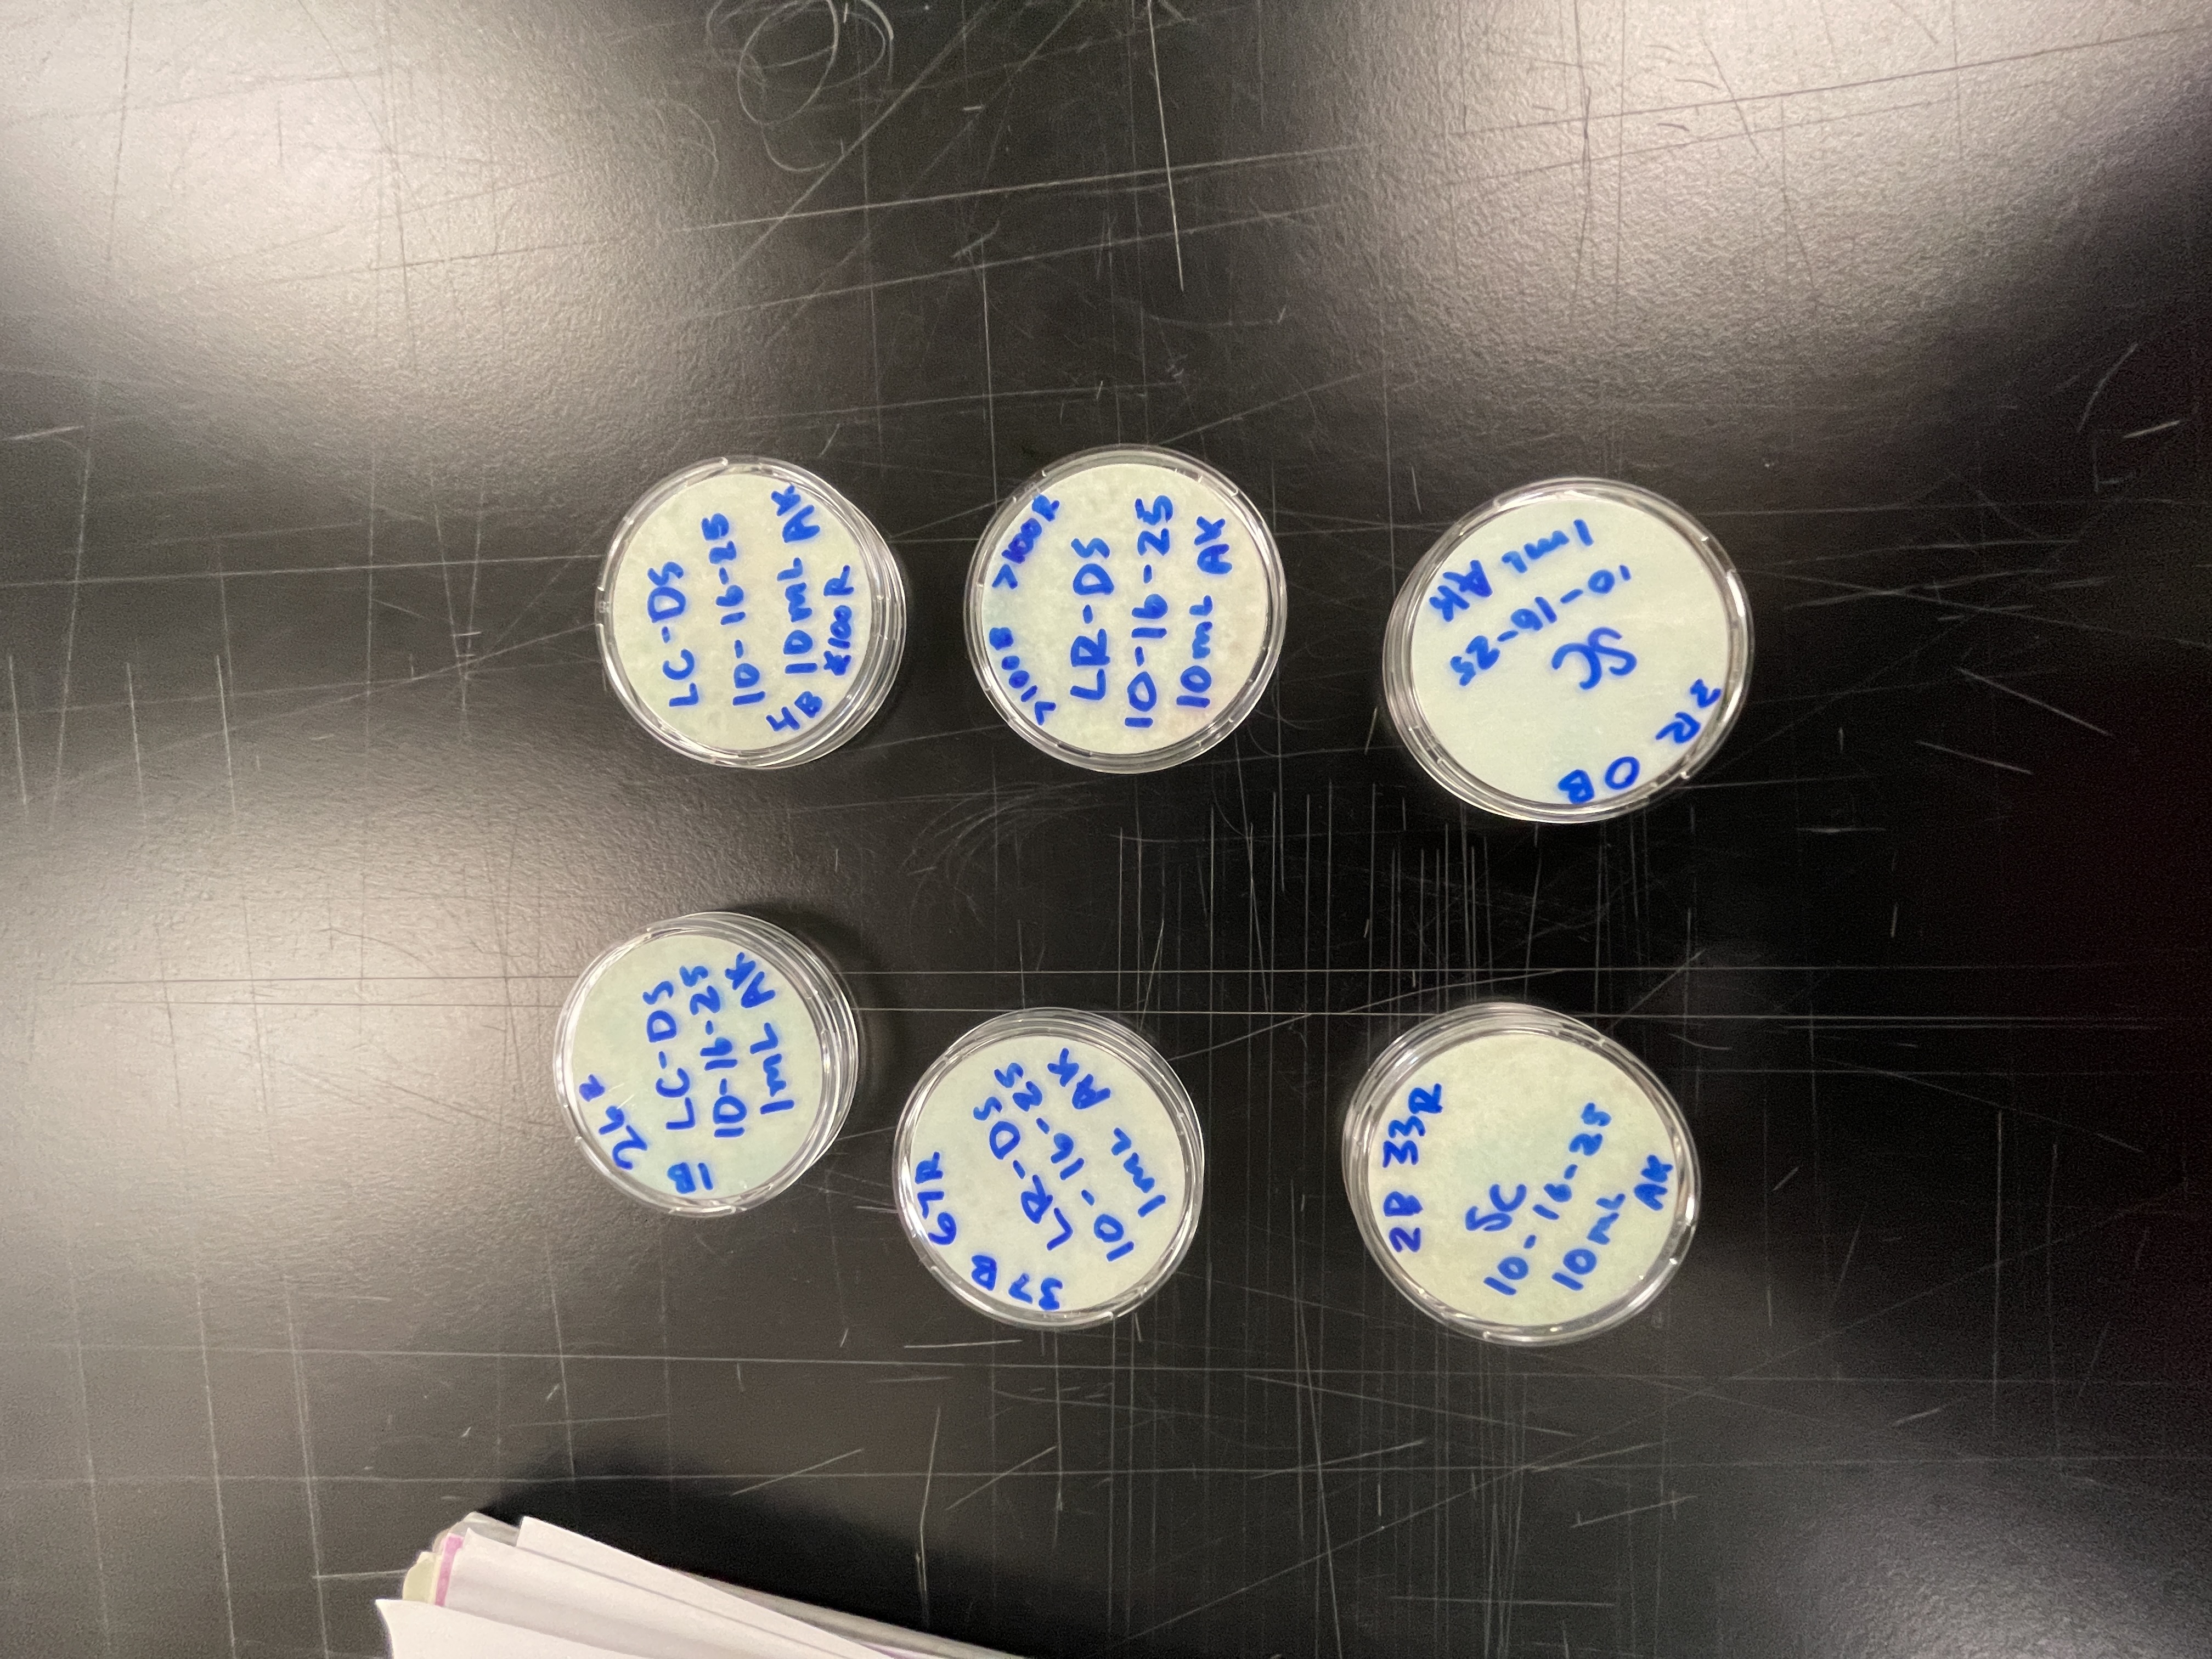
Samples
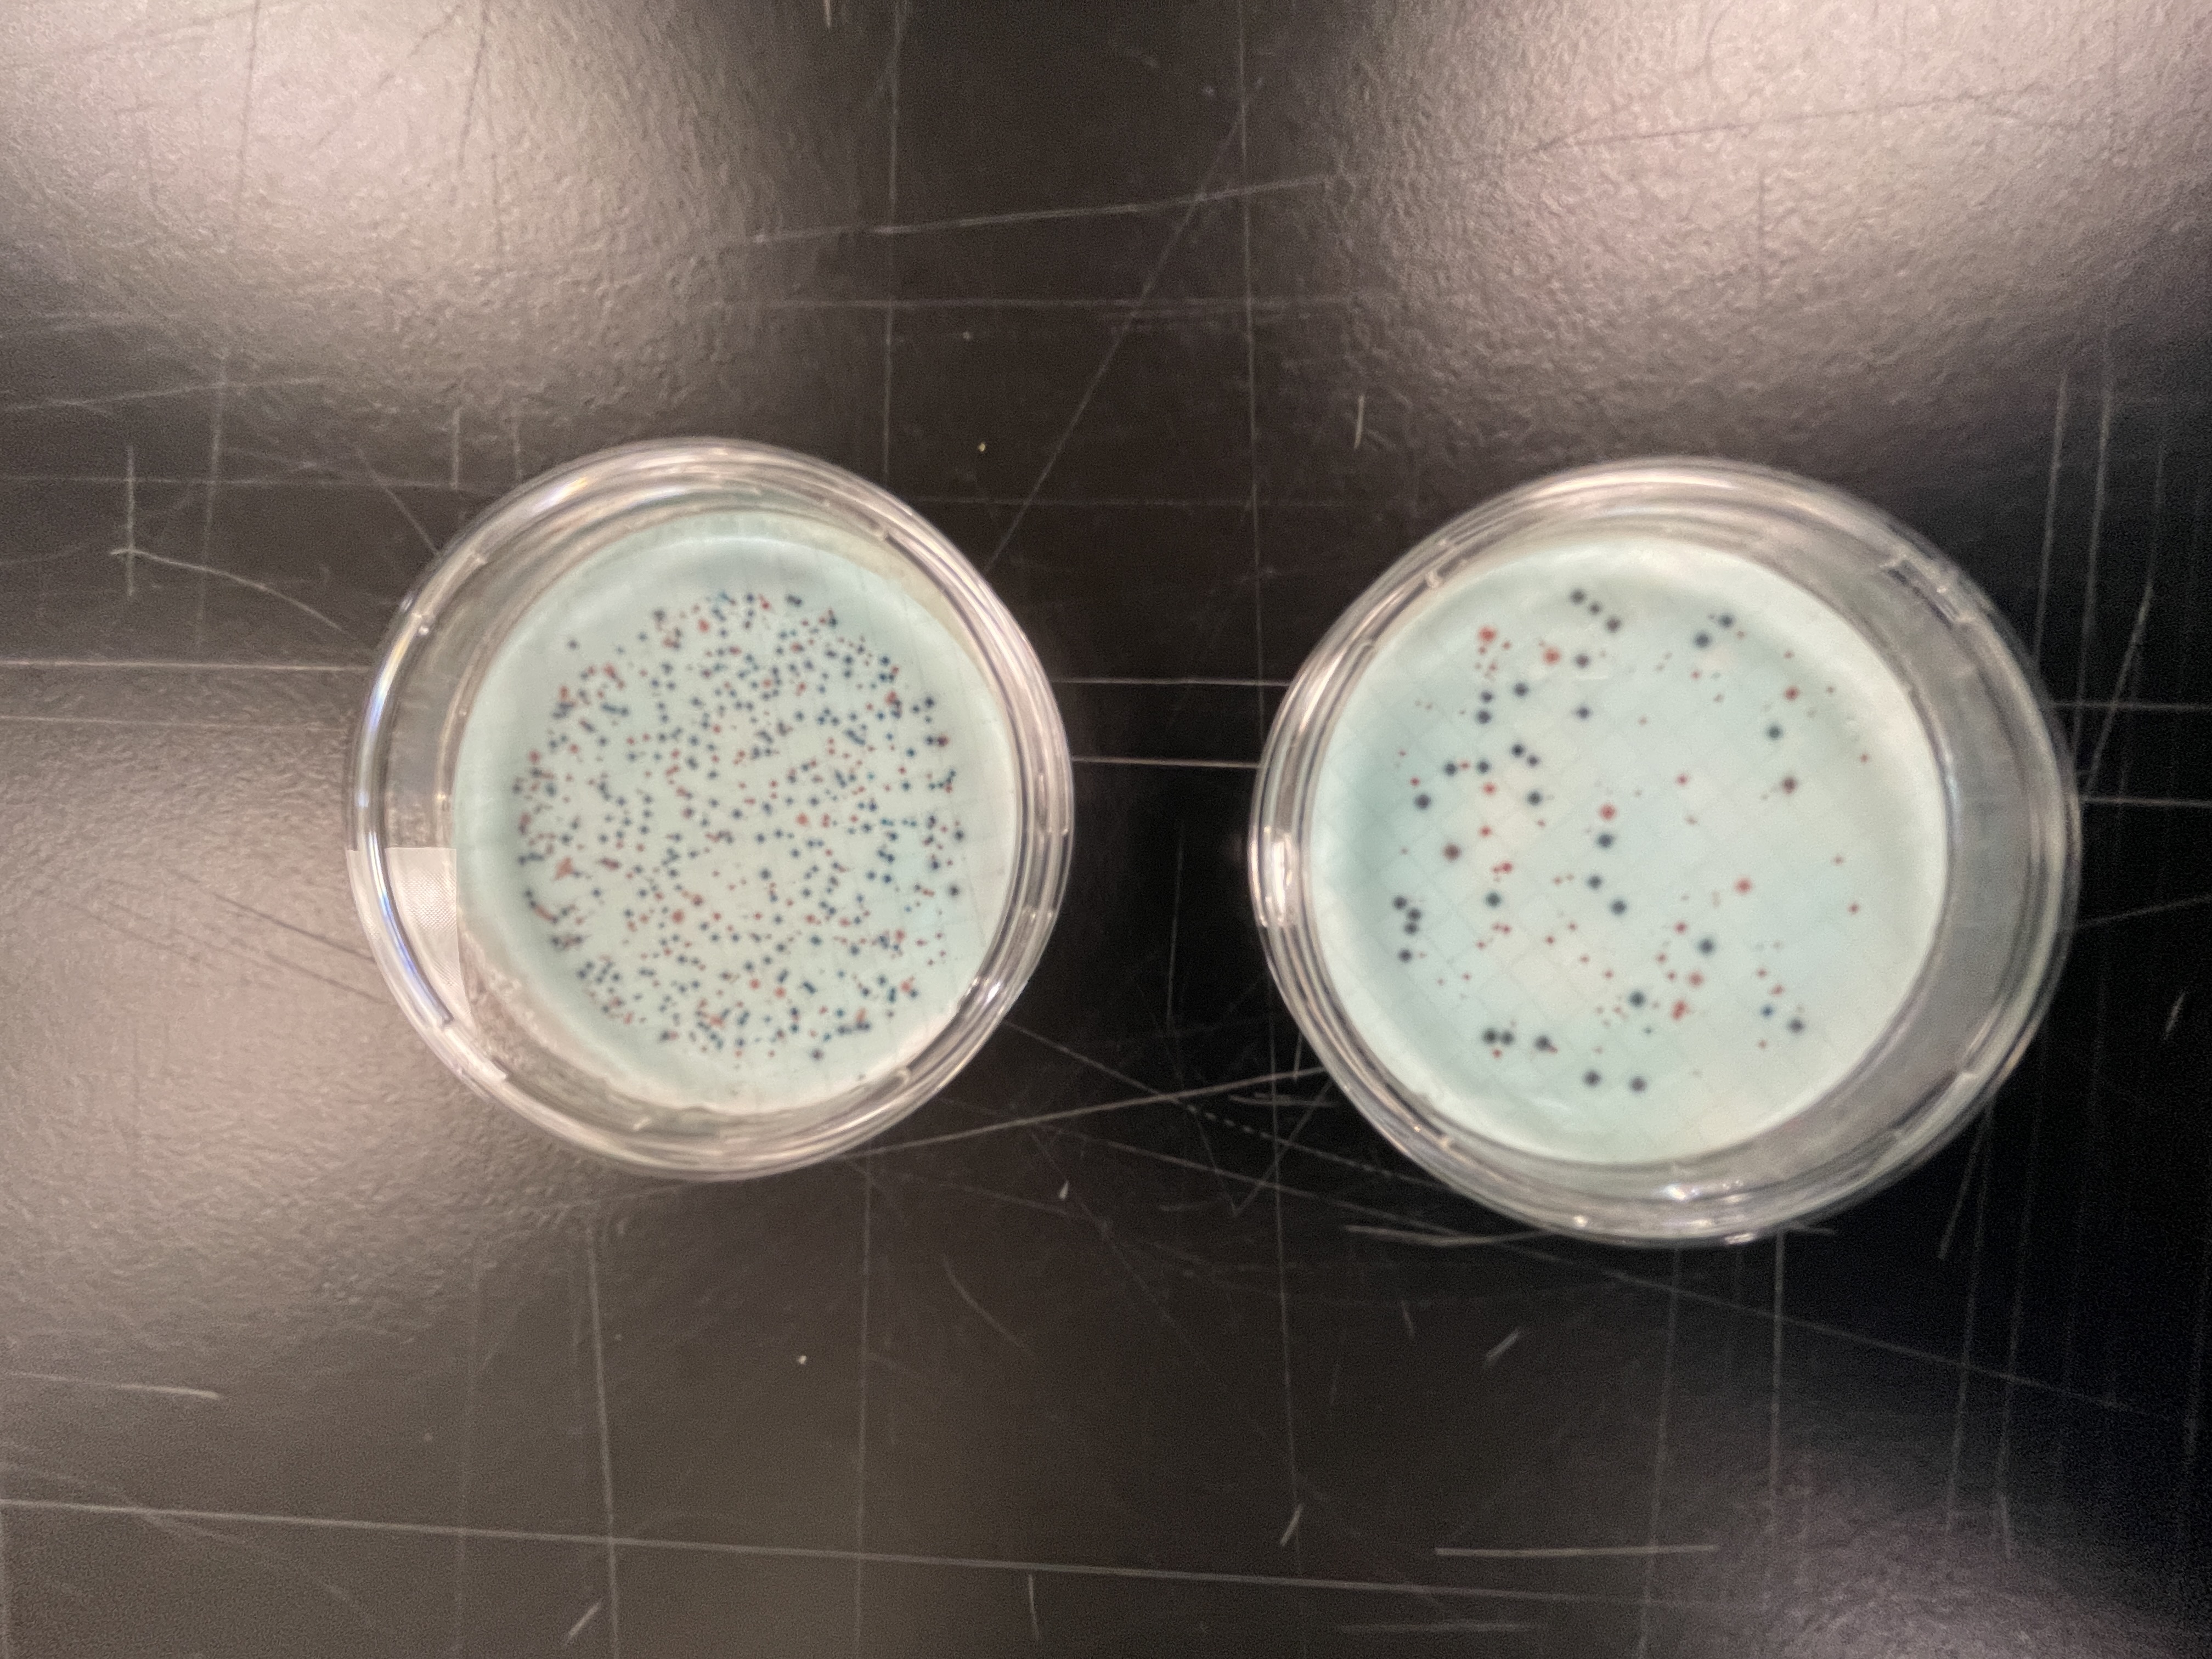
Sample comparison

Project Overview
The Lehigh Valley Water Quality Analytics project focuses on analyzing and monitoring water quality parameters throughout the Lehigh Valley region to better understand local water resources and environmental impacts.

Objectives
- Collect and analyze water quality data from various sources in the Lehigh Valley
- Develop analytical tools and methodologies for water quality assessment
- Create reports and visualizations to communicate findings to the community
- Collaborate with local environmental organizations and government agencies
Current Activities
Our team is currently working on developing a comprehensive database of water quality parameters and implementing advanced analytics to identify trends and potential issues in the local water supply.
Impact
This project aims to provide valuable insights to local communities and decision-makers to help protect and improve water quality in the Lehigh Valley region.
Get Involved
Students interested in environmental engineering, data analysis, and community engagement are encouraged to join this project. Contact us to learn more about opportunities to contribute.